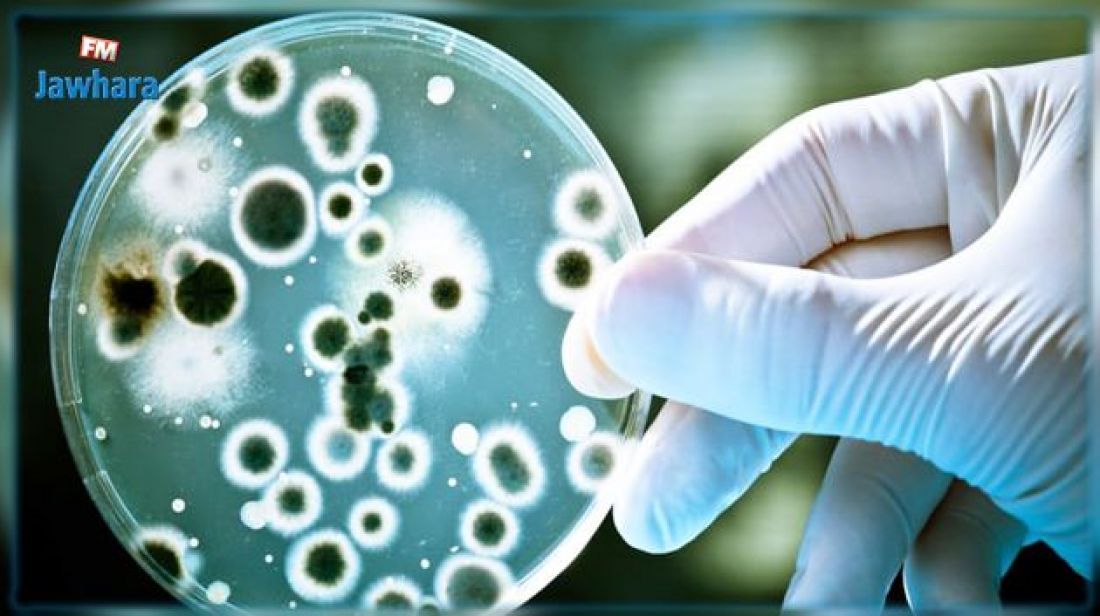

- الإعلانات -
زغوان: 4 إصابات بعدوى شيغالا في صفوف الأطفال
- الإعلانات -
أفاد المدير الجهوي للصحة بزغوان الدكتور كريم لحسيني أن 4 أطفال أعمارهم دون الثماني سنوات أصيبوا بعدوى شيغالا بزغوان تم ايواء اثنين منهم بقسم الأطفال بالمستشفى الجهوي بزغوان وآخرين بمستشفى الأطفال بتونس، قبل أن يعودوا جميعا إلى عائلاتهم مع تحسن حالاتهم الصحية.
وأضاف الدكتور لحسيني، في تصريح لمراسلة الجوهرة اف ام، أن المصالح الصحية بالجهة بالتنسيق مع مختلف الهياكل المتداخلة تعمل على تكثيف عمليات التحسيس بمخاطر المرض وطرق الوقاية منه بمؤسسات الطفولة والمؤسسات التربوية ومختلف الفضاءات الاجتماعية وذلك بالدعوة إلى الحرص على نظافة الأيدي وغسلها جيدا بالماء والصابون قبل الأكل وبعد الدخول إلى دورات المياه وقص الأظافر والحرص أيضا على تنظيف الوحدات الصحية العمومية وتعقيمها داعيا الأولياء إلى الانتباه إلى صحة أطفالهم ومراقبتهم والتأكيد على نظافة أياديهم.
وبين الدكتور لحسيني أن المصالح الصحية بالجهة اتخذت التدابير الضرورية داخل المستشفيات فيما يتعلق بالنفايات الصحية والتوصيات الموجهة للاطارات الطبية وشبه الطبية فضلا عن العمل على تكثيف التحاليل للحالات المشتبه إصابتها بهذه العدوى لضمان نجاعة التدخل المبكر ومنع تطور المرض في حالة الإصابة المؤكدة كما تعمل بالتنسيق مع مصالح المراقبة الصحية على مراقبة جودة المياه والتصدي لعمليات بيع المياه بطرق عشوائية.
عواطف خلف
#زغوان #إصابات #بعدوى #شيغالا #في #صفوف #الأطفال
تابعوا Tunisactus على Google News
- الإعلانات -
